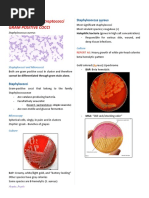

0% found this document useful (0 votes)
95 views7 pagesMidterms Lab Complete
The document discusses inoculation techniques and procedures for microbiology testing. It describes how to isolate microorganisms using inoculating wires or loops on different types of culture media like tubes, slants, or plates. Various streaking patterns are explained for transferring microbes on solid media. Chemical disinfection tests and preparing standardized bacterial concentrations using McFarland standards are also summarized. Antimicrobial susceptibility testing methods like Kirby-Bauer disk diffusion are outlined.
Uploaded by
Carina DaduloCopyright
© © All Rights Reserved
We take content rights seriously. If you suspect this is your content, claim it here.
Available Formats
Download as PDF, TXT or read online on Scribd
0% found this document useful (0 votes)
95 views7 pagesMidterms Lab Complete
The document discusses inoculation techniques and procedures for microbiology testing. It describes how to isolate microorganisms using inoculating wires or loops on different types of culture media like tubes, slants, or plates. Various streaking patterns are explained for transferring microbes on solid media. Chemical disinfection tests and preparing standardized bacterial concentrations using McFarland standards are also summarized. Antimicrobial susceptibility testing methods like Kirby-Bauer disk diffusion are outlined.
Uploaded by
Carina DaduloCopyright
© © All Rights Reserved
We take content rights seriously. If you suspect this is your content, claim it here.
Available Formats
Download as PDF, TXT or read online on Scribd
/ 7